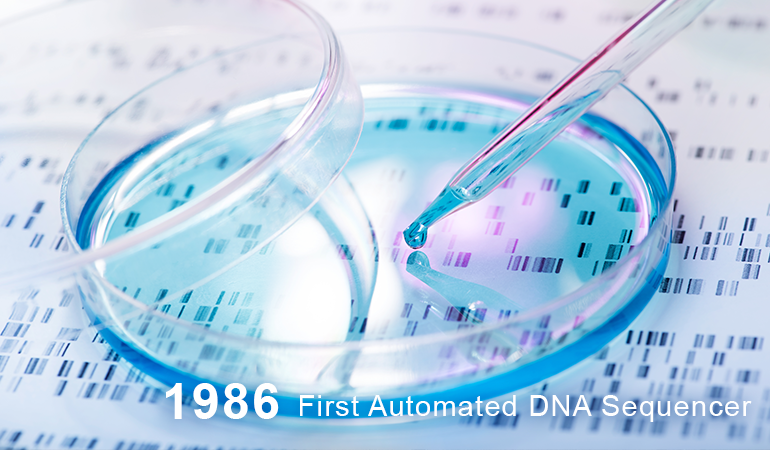

Impact
Pushing interdisciplinary boundaries in the service of discovery
Culture of Innovation at Caltech
With focus, ambition, and perspective, Caltech's researchers venture into unexplored realms, define new fields, and push interdisciplinary boundaries in the service of discovery. What happens here is proof that, with the right resources and environment, a small community of scholars can have world-changing impact.
Since its founding, Caltech researchers have displayed an innovative spirit. Caltech scientists and engineers have invented...

1930s – Built the tools to measure earthquakes (Richter Scale)

1934 – Invented the pH Meter

1960's – Integrated circuit design behind computer chips

1970s – Connected the World (Fiber Optic Cables)
1986 – First Automated DNA Sequencer

1990s – Frances Arnold pioneered the technique of directed evolution

1995 – Sensors enable mobile phone cameras

mid 1990s – Championed treatment of HIV/AIDS

2005 – Discovery of metal compound that facilitates metathesis
OTTCP was founded in 1995 to help foster Caltech's long-standing tradition of innovation and entrepreneurship. Since then, we have focused on creating an ecosystem to increase the number of technologies successfully commercialized for greater societal impact.